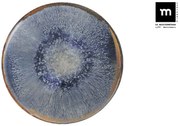
Основна чиния LA MEDITERRANEA Aelia, 32.5 cm

Продукти, които може да харесате
Порцеланова чиния Laerke, ø 25,6 cm - Green Gate
История на цените
- 2.12.2025 г. - 64,8 лв. / 33,13 €
- 28.11.2025 г. - 64,8 лв. / 33,13 €
- 5.11.2025 г. - 40,39 лв. / 20,65 €
- 3.07.2024 г. - 65 лв. / 33,23 €
- 26.06.2024 г. - 81 лв. / 41,41 €
- 20.06.2024 г. - 65 лв. / 33,23 €
- 18.06.2024 г. - 81 лв. / 41,41 €
- 26.02.2024 г. - 37 лв. / 18,92 €
Описание на продукта
Обичате очарованието на английската провинция? Тогава ще харесате марката Green Gate и нейните ръчно изработени съдове и други кухненски аксесоари. С деликатния си дизайн, фино украсен с романтични мотиви, той издига дори обикновената трапеза в почти празничен повод.
Спецификации
| Форма на плочите | Квадратен, Атипични |
|---|---|
| Материал на чиниите | Порцелан |
| Материал | Порцелан |
| Вид чиния | Вечеря |
| Форма | Кръгъл |
| Серия | Laerke |
| Модел | На цветя |
| Качество | Екстра |
| Инструкции | Подходящ за микровълнова/подходящ за съдомиялна машина |
| Производител | Green Gate |
Препоръчва се

Комплект чинии от 18 части Medicea - Brandani
Комплект, порцелан, десерт

Bonna - Grain - Чиния 17cm (GRA GRM 17DZ)
Порцелан, модерни
Най-добрите продукти от Bonami

Тъмносин комплект за хранене от каменна керамика 24 бр. Glosia - Bonami Selection

Матово черно пластмасово кошче за боклук с педал 45 l Chic Bin – KIS
С капак, пластмаса, за смесени отпадъци

Кош за пране от дърво и плат Kankyo 62 L - Premier Housewares
Квадратна, платнена торба за пране, отворен

Единично памучно детско спално бельо 140x200 cm Bluey – Jerry Fabrics
140×200 cм, в детско легло, класически

Седалка за тоалетна 37 x 42,5 cm Bamboo – Wenko
Класически, дърво
Предлага се в 2 онлайн магазинa

Бял стоманен допълнителен рафт 25x25 cm Silos – Metaltex
Рафт, пластмаса, метал

Бежово капитонирано покривало за легло от жакард 240x260 cm Opulent Jacquard – Catherine Lansfield
240×260 cм

Стоманен разтегателен двоен корниз 213 - 365 cm Twilight – Umbra
Метал

Бяла поставка за тоалетна хартия с четка за тоалетна Imon - Wenko
С държачи за тоалетна хартия, пластмаса
Предлага се в 2 онлайн магазинa

Сушилня за дрехи Infinity Flex - Vileda
Интериор, стоящи

Синьо детско спално бельо Футбол, 135 x 200 cm - Catherine Lansfield
Футбол, за момчета, в детско легло

Стоманена поставка за тоалетна хартия стойка с четка в черен и естествен цвят Pomarolo – Wenko

Пластмасов кош за пране 50 l Brisen - Rotho
Квадратна, пластмаса, отворен

Кош за отпадъци за баня от неръждаема стомана в златисто Leman - Wenko
Стъпало, с капак
Предлага се в 2 онлайн магазинa

Кремав детски килим 160x235 cm Funny Dots – Hanse Home
Класически, правоъгълно

Комплект кофа и моп за под Turbo 3в1 Turbo 3v1 - Vileda

Черно кошче за боклук с капак, 41 x 33 x 62,5 cm - Addis
С капак, педал, пластмаса

Кремава и златисто настолна лампа (височина 47 cm) – Opviq lights
Ключ за осветление, на нощното шкафче
Предлага се в 2 онлайн магазинa